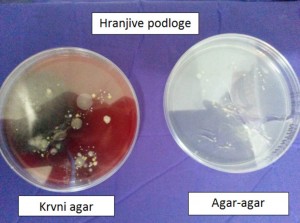
higijena01

HIGIJENA U ŠKOLI – Sad nešto drugačije…
Učenici četvrtog d razreda, smjera dentalni tehničar, slušaju predmet Mikrobiologiju.
U suradnji sa ZAVODOM ZA JAVNO ZDRAVSTVO i mikrobiologom dr. Zvonimirom Barišićem odlučili smo nastavu mikrobiologije učiniti interesantnijom i praktičnijom.
Nakon što smo naučili vrste bakterija, došao je red na njihove kolonije koje se uzgajaju na tzv.hranjivim podlogama. Dobili smo dvije hranjive podloge: agar-agar i krvni agar. S podlogom agar-agar prošli smo kroz razred i „pokupili“ sve bakterije, mikroorganizme i gljivice-plijesni iz zraka, a na krvni agar jedan učenik je ostavio otisak svoga dlana.
Pustili smo da se bakterijske kolonije razvijaju u toploj sredini anatomskog kabineta, sedam dana.
Nakon sedam dana uočili smo sljedeće stanje a koje možete vidjeti i na priloženim slikama:
- na hranjivoj podlozi agar-agar nije bilo okom vidljivig kolonija, što ukazuje da su nam učionice IZUZETNO čiste
- na hranjivoj podlozi krvnog agara našli smo destak vrsta bakterijskih i drugih kolonija, što ukazuje da vrlo lako rukama prenosimo uzročnike bolesti.
Međutim, poznata nam je činjenica da koliko god prali ruke, na njima uvijek nalazimo jedan broj patogenih klica i mnoštvo saprofita.
Ipak, zajednički smo došli do zaključka da ruke treba prati i više i češće, osobito sad kad dolazi sezona prehlada i gripe te ovim putem izražavam javnu pohvalu našim djelatnicama, teti Ani i Ljubi, koje se brinu o čistoći i higijeni naše škole.
Dr.med. Smilja Senković Pezelj, nastavnica i moderator
Traži:
Kategorije
- Demo centar (4)
- Događaji (26)
- Natječaji (35)
- Natjecanja (5)
- Nekategorizirano (10)
- Obrazovanje (102)
- EEEDT (1)
- IOSS (7)
- Obrazovanje odraslih (8)
- Obrazovanje uz rad u fizikalnoj terapiji (17)
- Redovno obrazovanje (8)
- Srednja škola (60)
- Općenito (3)
- Tečajevi (2)
- Zanimljivosti (3)